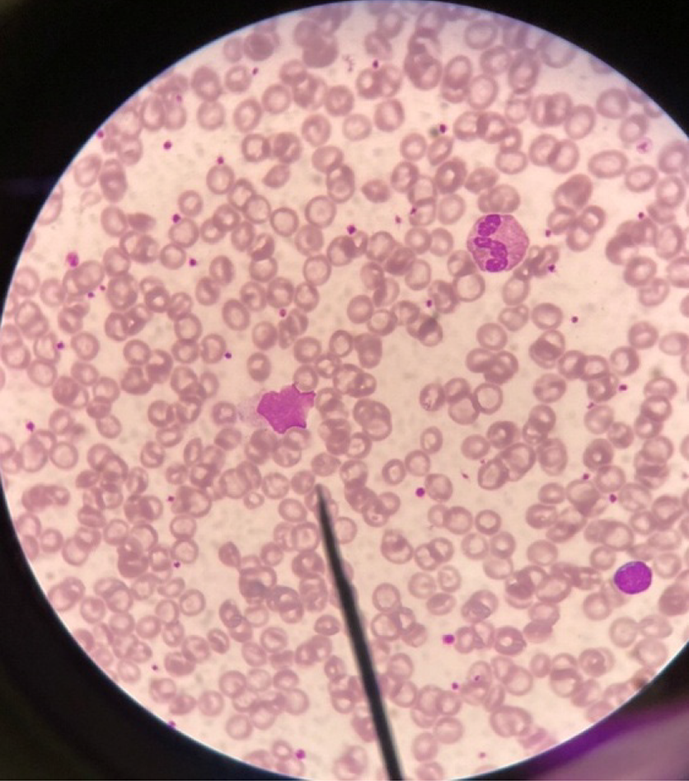

©The Author(s) 2026.
World J Hepatol. Feb 27, 2026; 18(2): 113686
Published online Feb 27, 2026. doi: 10.4254/wjh.v18.i2.113686
Published online Feb 27, 2026. doi: 10.4254/wjh.v18.i2.113686
Figure 1 A 17-month-old girl who underwent liver transplantation 7 months ago presented with an enlarged lymph node with a diameter of up to 1.
5 cm in the left cervical region. Lymph node biopsy revealed atypical lymphoproliferation of CD3+, CD20-, and Epstein-Barr-encoded RNA+ cells. She developed a skin lesion that spread from her face to her feet. Skin biopsy and immunohistochemistry findings are consistent with monoclonal T-cell lymphoma. A: Multiple maculopapular rash scattering at thigh and limb; B: Multiple maculapapular rash scattering at forehead.
Figure 2 A 4-year-old boy who underwent liver transplantation 3 years ago presented with a subacute fever and abdominal pain.
Supine abdominal radiograph showed free intraperitoneal air (white triangle in Figure 2A) and an infiltrative lesion at the duodenojejunal site, a 6 cm mass with a large perforation site at the duodenojejunal junction. Computed tomography images 7 days after exploratory laparotomy showed segmental, irregular bowel wall thickening and aneurysmal dilation of a jejunal loop in the left upper to mid-abdomen (white arrows), matted mesenteric lymph nodes (black triangle), and an enlarged para-aortic lymph node (white triangle). A: Abdominal X-ray; B: Operative finding; C-F: Computed tomography abdomen (cross section).
Figure 3 A 34-month-old girl who underwent a liver transplant 6 months ago presented with pale, hypoalbuminemia, and mucous diarrhea.
Esophagogastroduodenoscopy and colonoscopy revealed generalized mucosal swelling with multiple shallow ulcers in the stomach and duodenum. Histopathological examination revealed an atypical lymphoproliferative lesion extending from the stomach to the rectum.
Figure 4
Downey cell.
Figure 5 Computed tomography images.
A and B: Computed tomography images of a 34-month-old girl who presented with pallor and mucous diarrhea after liver transplantation showed large, matted mesenteric lymph nodes (white arrows); C: A few small bowel loops with focal wall thickening (white arrowheads); D: A hypoenhancing lesion in the right kidney (black triangle).
Figure 6 Duodenum of a 34-month-old girl.
A: Hematoxylin and eosin staining shows small bowel mucosa with distorted architecture. The lamina propria comprises a lymphoproliferative lesion comprising medium- to large-sized lymphoid cells; B: CD20 staining is positive; C: Ki-67 staining is positive (90%); D: Epstein-Barr-encoded RNA staining is positive.
Figure 7 Lymph node of a 17-month-old girl.
A: Hematoxylin and eosin staining (× 20) shows architectural effacement with numerous atypical round cells in a necrotic background. These cells have medium- to large-sized hyperchromatic nuclei, indistinct nucleoli, and scant cytoplasm; B: CD3 staining is positive.
Figure 8 Suggested algorithm for monitoring and treatment Epstein-Barr virus infection in liver-transplant children.
EBV: Epstein-Barr virus; PCR: Polymerase chain reaction; D: Donor; R: Recipient; VL: Viral load; RIS: Reduce immunosuppressant.
- Citation: Onpoaree N, Leelakanok N, Sanpavat A, Sintusek P. Epstein-Barr virus infection in children with liver transplantation. World J Hepatol 2026; 18(2): 113686
- URL: https://www.wjgnet.com/1948-5182/full/v18/i2/113686.htm
- DOI: https://dx.doi.org/10.4254/wjh.v18.i2.113686